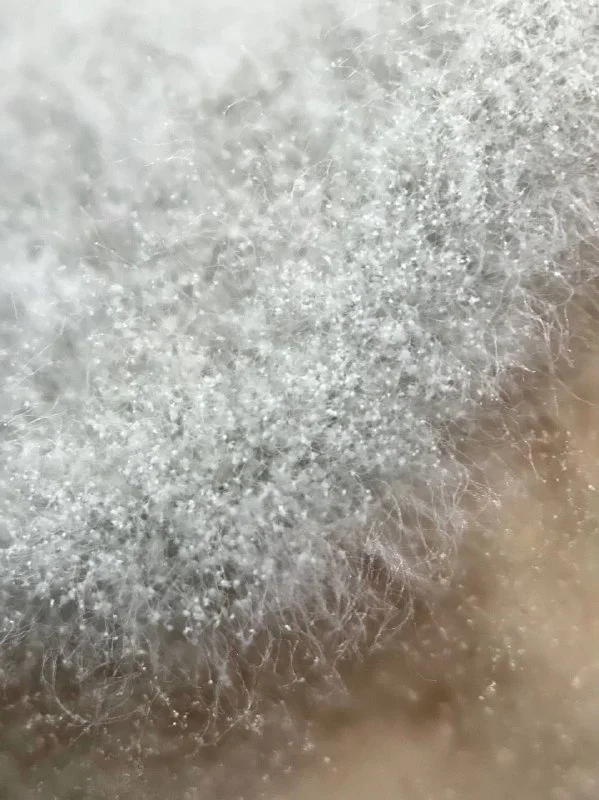
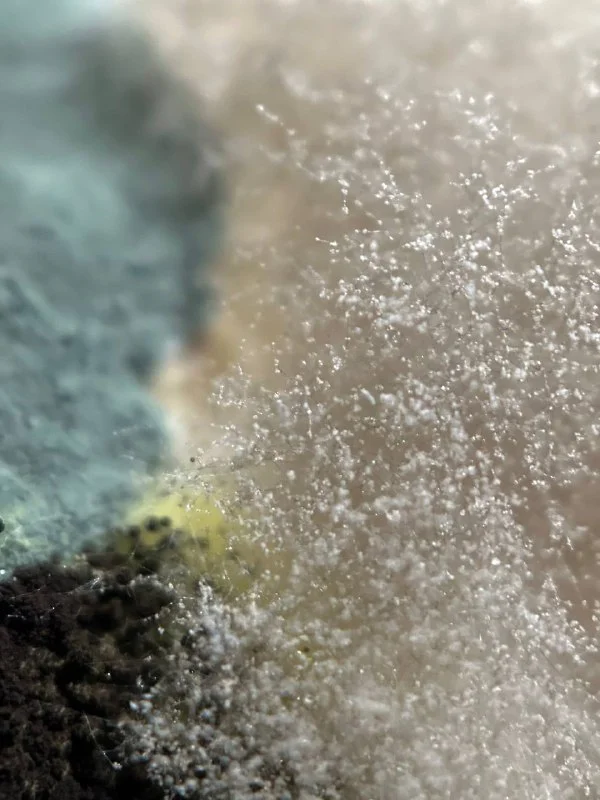
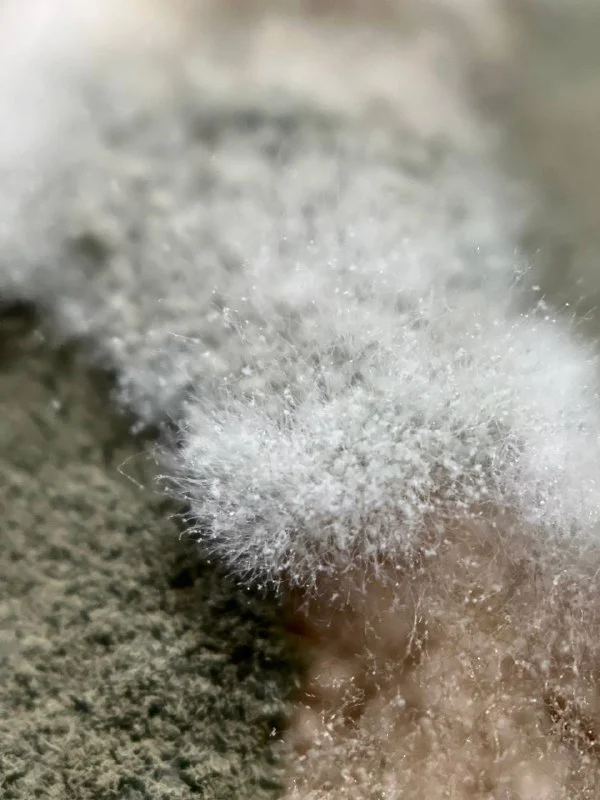
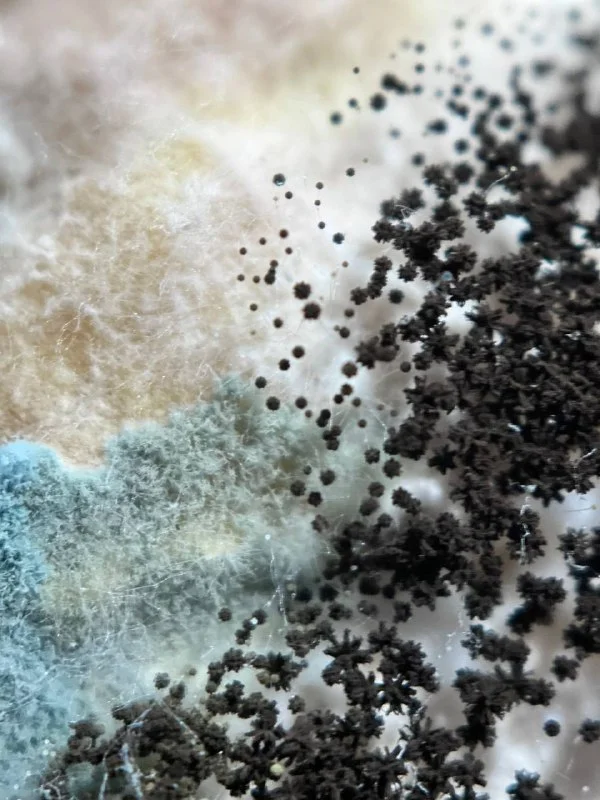

Channels / Кипр: фото
Кипр: фото
@cyprus_photo · supergroup
Day 52 (21.02.2025), #manushinaalla @manushinaalla #day52
Streak: 52/52/52
Streak: 52/52/52
Day 51 (20.02.2025), #Forest_h @Forest_h #day51
Streak: 19/19/24
Streak: 19/19/24
Day 52 (21.02.2025), #kochevanov @kochevanov #day52
Streak: 52/52/52
Streak: 52/52/52
Day 51 (20.02.2025), #katy_navy @katy_navy #day51
Streak: 41/41/41
Streak: 41/41/41
Day 52 (21.02.2025), #nata_kochukova @nata_kochukova #day52
Streak: 7/25/32
Streak: 7/25/32
Day 52 (21.02.2025), #sun_worshiper @sun_worshiper #day52
Streak: 3/47/50
Streak: 3/47/50
Продаю вспышку YONGNUO 560 IV и синхронизатор к ней. В отличном состоянии, все работает. 150€. Лимассол.
Sergey Vinogradov
2025-02-21 14:36 UTC
CyprusPhotoBot
Day 52 (21.02.2025), #nata_kochukova @nata_kochukova #day52
Streak: 7/25/32
Прям в голове зазвучало "Станция Новослободская, переход на станцию Менделеевская Серпуховско-Тимирязевской линии"
Denis Davydov
2025-02-21 14:37 UTC
Denis Davydov
ПРОДАЮ
Поскольку оба объектива нашли себе хозяев, осталась только камера. Имеет смысл обновить пред...
актуально! Продам за 700 но срочно надо.
Denis Davydov
2025-02-21 14:37 UTC
лежит без дела
Vilen
2025-02-21 14:42 UTC
Denis Davydov
актуально! Продам за 700 но срочно надо.
А на базараки выкладывал? Был бы я кеноновод забрал бы за такую цену
Denis Davydov
2025-02-21 14:43 UTC
Vilen
А на базараки выкладывал? Был бы я кеноновод забрал бы за такую цену
щас проверю не обновлял навеное
Day 52 (21.02.2025), #Ksen_Kas @Ksen_Kas #day52
Streak: 31/31/31
Streak: 31/31/31
Katrina Sid
2025-02-21 14:53 UTC
Продам:
1. Sigma 28-70mm f/2.8 DG DN Contemporary Lens for Sony E Mount - 550€ (в комплекте все крышечки, бленда и коробка)
2. SIGMA Art 135mm F1.8 DG HSM for SONY E Mount - 850€ (в комплекте все крышечки, бленда, фирменный чехол, гарантийные бумажки, коробка есть в России, если очень нужно можно что-то придумать 😁)
Год покупки 2022, один хозяин, территориально Пафос, по выходным могу подъехать в другие города
1. Sigma 28-70mm f/2.8 DG DN Contemporary Lens for Sony E Mount - 550€ (в комплекте все крышечки, бленда и коробка)
2. SIGMA Art 135mm F1.8 DG HSM for SONY E Mount - 850€ (в комплекте все крышечки, бленда, фирменный чехол, гарантийные бумажки, коробка есть в России, если очень нужно можно что-то придумать 😁)
Год покупки 2022, один хозяин, территориально Пафос, по выходным могу подъехать в другие города
Day 52 (21.02.2025), #special_linear @special_linear #day52
Streak: 1/1/2
Streak: 1/1/2
Day 52 (21.02.2025), #akorneevaa @akorneevaa #day52
Streak: 1/23/38
Streak: 1/23/38
Day 52 (21.02.2025), #marinakotidze @marinakotidze #day52
Streak: 52/52/52
Streak: 52/52/52
Day 52 (21.02.2025), #bula_EVA @bula_EVA #day52
Streak: 52/52/52
Streak: 52/52/52
Day 52 (21.02.2025), #koshkinalex @koshkinalex #day52
Streak: 52/52/52
Streak: 52/52/52
Day 51 (20.02.2025), #nektata @nektata #day51
Streak: 51/51/51
Streak: 51/51/51
Day 52 (21.02.2025), #VilenSharifov @VilenSharifov #day52
Streak: 52/52/52
Streak: 52/52/52
Day 52 (21.02.2025), #Bonjovi6 @Bonjovi6 #day52
Streak: 5/22/46
Streak: 5/22/46
Day 52 (21.02.2025), #nektata @nektata #day52
Streak: 52/52/52
Streak: 52/52/52
Elbereth Gilthoniel
2025-02-21 19:40 UTC
CyprusPhotoBot
Day 52 (21.02.2025), #special_linear @special_linear #day52
Streak: 1/1/2
Не могу отделаться от мысли, что он мне Хабенского напоминает ))
Day 51 (20.02.2025), 1 place, #cy365 #ElaReProduction @ElaReProduction https://t.me/photo_cyprus/1281
CyprusPhotoBot
2025-02-21 22:00 UTC
Results for the Day 51 (20.02.2025):
@ElaReProduction
@manushinaalla
@Ksen_Kas
@StefanosKouratzis
@bula_EVA
@rodi_stas
@VilenSharifov
@whoisarti
@nektata
@marinakotidze
@nata_kochukova
@katy_navy
@koshkinalex
@Bonjovi6
@Forest_h
@kochevanov
@sun_worshiper
#cy365 #day51
@ElaReProduction
: 31❤️ / 1👎@manushinaalla
: 21❤️ / 2👎@Ksen_Kas
: 14❤️@StefanosKouratzis
: 13❤️@bula_EVA
: 12❤️@rodi_stas
: 11❤️@VilenSharifov
: 11❤️@whoisarti
: 11❤️ / 1👎@nektata
: 11❤️ / 1👎@marinakotidze
: 8❤️ / 1👎@nata_kochukova
: 8❤️ / 2👎@katy_navy
: 7❤️@koshkinalex
: 6❤️ / 4👎@Bonjovi6
: 5❤️ / 2👎@Forest_h
: 4❤️ / 1👎@kochevanov
: 2❤️ / 1👎@sun_worshiper
: 2❤️ / 1👎#cy365 #day51
Day 51 (20.02.2025), 3 place, #cy365 #Ksen_Kas @Ksen_Kas https://t.me/photo_cyprus/1286
Day 51 (20.02.2025), 2 place, #cy365 #manushinaalla @manushinaalla https://t.me/photo_cyprus/1279
Day 52 (21.02.2025), #Forest_h @Forest_h #day52
Streak: 20/20/25
Streak: 20/20/25
53 messages on this day